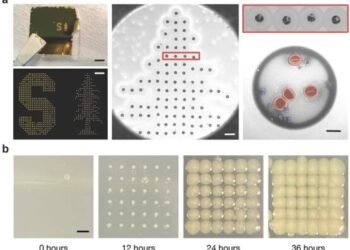
Development of cost-effective and strong carbon fiber composites using carbon nanotubes. Nano Digest.

Nanotechnology in Cancer
September 10, 2020
New research methods developed for nano and quantum materials
February 24, 2023
Emergence of 2.5D Materials for Futuristic Applications
June 29, 2022
A Highly Sensitive Quantum Microscope Developed
April 1, 2026
Wristband enables wearers to control a robotic hand
March 26, 2026
Why you can’t tie knots in four dimensions
March 20, 2026